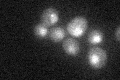
YFR031C
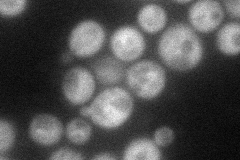
YFR031C
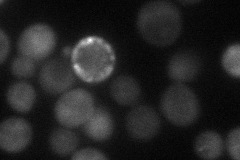
YFR031C
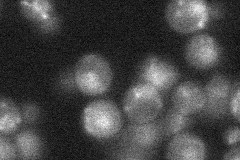
YFR031C
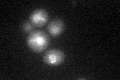
YFR031C

View description
Subunit of the condensin complex; essential SMC chromosomal ATPase family member that forms a complex with Smc4p to form the active ATPase; Smc2p/Smc4p complex binds DNA; required for clustering of tRNA genes at the nucleolus
Localization:
Intensity:
Fold change:
Significance:
-
C’ GFP library in SD
nucleus24.72 -
N' NOP1pr-GFP in SD
cytosol,punctate63.8432 -
N' TEF2pr-mCherry in SD
cytosol42.7679 -
N' NATIVEpr-GFP in SD
punctate,nucleus19.9158 -
N' TEF2pr-VC and Cyto-VN in SD

#N/A0 -
C’ GFP library in SD+DTT
nucleus23.590.95No -
C’ GFP library in SD+H2O2

nucleus27.271.1No -
C’ GFP library in Starvation Media

nucleus23.480.94No -
C’ GFP library on the background of Pup2-DaMP

nucleus -
C’ GFP library on the background of CCT mutant

nucleus28.18341.13964No
